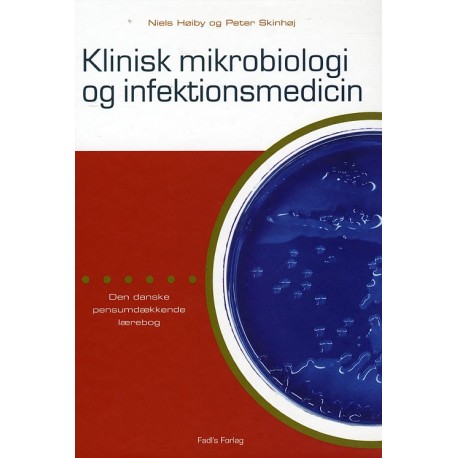

Kurv
Vare
varer
(tom)
Ingen varer
Fastlægges senere
Forsendelse
0,- kr
I alt
Klinisk Mikrobiologi og Infektionsmedicin
(Bog, Indbundet, Dansk)
Nedsat pris!

Beskrivelse
Klinisk Mikrobiologi og infektionsmedicin er en udvidet udgave af den tidligere mikrobiologiske lærebog Basal og Klinisk Mikrobiologi. Den er tilpasset den nye studieordning, hvor medicinsk mikrobiologi og infektionsmedicin er stærkt integreret. Den rivende udvikling i fagområderne afspejler sig i en række nye forfattere med specialkyndig baggrund og omfattende præ- og postgraduat undervisningerfaring. Bogen henvender sig til medicinske studenter, tndlægestuderende, bioanalytikerstuderende samt til læger, tandlæger og bioanalytiker. Bogen dækker eksamenspensum ved det medicinske og odontologiske studium.
Læsernes anmeldelser (0)
Alle detaljer
| Forlag | FADL |
| Forfatter | Niels V. Høiby & Peter Skindhøj |
| Type | Bog |
| Format | Indbundet |
| Sprog | Dansk |
| ISBN-13 / EAN-13 | 9788777494239 |


